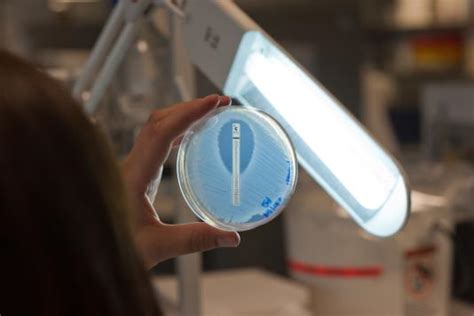

IABC News: Republicans Discuss Key Issues
IABC News: Republicans Discuss Key Issues
What’s the latest buzz in the Republican party, guys? At IABC News, we’re diving deep into the conversations shaping the political landscape. Republicans are constantly navigating a complex web of policy debates, strategic planning, and public engagement. From economic strategies to social issues, their discussions are pivotal to understanding the direction of the party and, by extension, the nation. We’re going to break down some of the key talking points that have been making headlines and influencing the GOP’s agenda. It’s not just about soundbites; it’s about understanding the underlying principles and the potential impact of their proposed policies. So, buckle up as we explore the multifaceted world of Republican politics through the lens of IABC News.
Table of Contents
Economic Policies: A Deep Dive into the Republican Agenda
When we talk about the Republican party, economic policy is almost always at the forefront of their discussions. Guys, it’s a core tenet of their platform. The GOP generally advocates for lower taxes, reduced government spending, and deregulation. The idea is that by trimming the fat from government and encouraging businesses to thrive without excessive oversight, the economy will naturally grow, creating jobs and opportunities for everyone. Think about the Tax Cuts and Jobs Act of 2017 – that was a significant piece of legislation driven by Republican principles, aiming to stimulate business investment and individual prosperity. Now, the effectiveness and fairness of such policies are always debated, and IABC News is here to present the different angles. Critics often point to potential increases in national debt or a widening gap between the wealthy and the working class. However, proponents argue that lower corporate taxes encourage companies to stay and invest in the U.S., rather than moving operations overseas, and that tax cuts for individuals leave more money in people’s pockets to spend and invest. It’s a complex equation with many variables, and the Republican approach often emphasizes market-driven solutions over government intervention. They believe that free markets are the most efficient way to allocate resources and generate wealth. This involves not just tax policy but also trade agreements, which Republicans often scrutinize to ensure they benefit American workers and industries. The conversation around spending also includes a focus on fiscal responsibility, with Republicans typically calling for cuts to government programs they deem inefficient or unnecessary. This can extend to discussions about entitlement reform, aiming to ensure the long-term solvency of programs like Social Security and Medicare, albeit with different approaches than their Democratic counterparts. At IABC News, we aim to provide you with the most comprehensive coverage , looking at the data, hearing from economists on all sides, and exploring the real-world implications for everyday Americans. Understanding these economic philosophies is crucial for anyone trying to make sense of the current political climate and the future of the economy .
Debates on Social Issues and Core Values
Beyond the economy, Republicans often engage in vigorous debates surrounding social issues and core values. These are the topics that resonate deeply with their base and often involve deeply held beliefs about family, faith, and individual liberty. For instance, issues like abortion, gun rights, and religious freedom are frequently discussed. The Republican platform typically emphasizes the protection of unborn life, the right to bear arms as guaranteed by the Second Amendment, and the importance of religious freedom in public life. You’ll often hear leaders talk about the sanctity of life and the need to defend constitutional rights. These aren’t just talking points; they represent fundamental aspects of the conservative worldview for many in the party. IABC News recognizes that these are often sensitive and deeply personal issues, and we strive to cover them with nuance and respect for diverse perspectives. While the party generally aligns on these core principles, there can be different approaches and priorities within the Republican ranks. Some may focus more heavily on legislative action, while others might emphasize cultural influence and education. The pro-life movement , for example, sees significant support within the GOP, with ongoing discussions about legislative strategies to restrict abortion access and provide support for alternatives. Similarly, the Second Amendment is a cornerstone for many Republicans, who view gun ownership as a fundamental right essential for self-defense and a check against potential government overreach. Discussions about religious freedom often center on ensuring individuals and organizations can practice their faith without government interference, sometimes leading to debates about the balance between religious freedom and other rights or non-discrimination laws. It’s a dynamic area, with constant evolution in how these issues are framed and addressed. At IABC News, we’re committed to bringing you balanced reporting that goes beyond the headlines, exploring the historical context, the legal arguments, and the social implications. We want you to understand the rationale behind these positions and the potential consequences, ensuring you have the information you need to form your own informed opinions.
The Role of National Security and Foreign Policy
When Republicans discuss national security and foreign policy, there’s often a strong emphasis on a robust military and projecting American strength on the global stage. Guys, this is a critical part of their identity and a major focus of their international relations strategy. The general sentiment is that a strong America deters adversaries and promotes stability worldwide. This translates into advocating for increased defense spending, maintaining a powerful military presence, and often taking a firm stance against perceived threats from nations like China and Russia. IABC News covers these discussions extensively. Think about the debates around defense budgets – Republicans are typically strong proponents of ensuring the military has the resources it needs to maintain technological superiority and readiness. They often emphasize the importance of alliances, but sometimes with a focus on ensuring those allies are contributing their fair share. When it comes to foreign conflicts and interventions, the approach can vary, but there’s often a leaning towards decisive action when American interests are perceived to be at stake. The concept of **